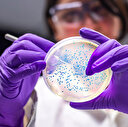

Koronavirüsün ortaya çıktığı ve salgının başında çok büyük kayıpların verildiği Çin'de hayat normale döndü. Ülkede 5 günlük İşçi Bayramı tatilinin ilk gününde 18,3 milyon tren yolculuğu yapılması bekleniyor. Çin halkı tatilin keyfini yaptığı yolculuklarla çıkarıyor.
Global Times gazetesinde yer alan habere göre, Çin Devlet Demiryolları Grubu, 5 günlük tatilde tekil tren yolculuklarının sayısının, 106 milyonu bulmasının beklendiğini açıkladı. Kuruluş, tatilin ilk gününde 18,3 tekil yolculuk yapılmasını beklediklerini bildirdi. Yolculuk sayılarının, koronavirüs salgını öncesindeki 2019 İşçi Bayramı'na kıyasla, tatilin ilk gününde yüzde 6,1, toplamda ise binde 8 artması bekleniyor.
- Artış, Kovid-19 salgının kontrol altına almayı başaran ülkedeki halkın güven duygusunun işareti olarak yorumlanıyor.
Çin Seddi ziyaretçi rezervasyonları limite yaklaştı
Öte yandan tarihi Çin Seddi'ni en çok ziyaretçi çeken bölgesi olan Pekin'in 80 kilometre kuzeyindeki Badaling'de 1-3 Mayıs tarihlerinde, Kovid-19 nedeniyle hafta sonları için belirlenen 50 binlik ziyaretçi limitine yaklaştığı, bu sabah itibarıyla 48 bin 750 rezervasyon yapıldığı bildirildi.
Kovid-19 salgınının ortaya çıktığı Çin, aldığı tedbirlerle salgını büyük ölçüde kontrol altına almayı başardı.